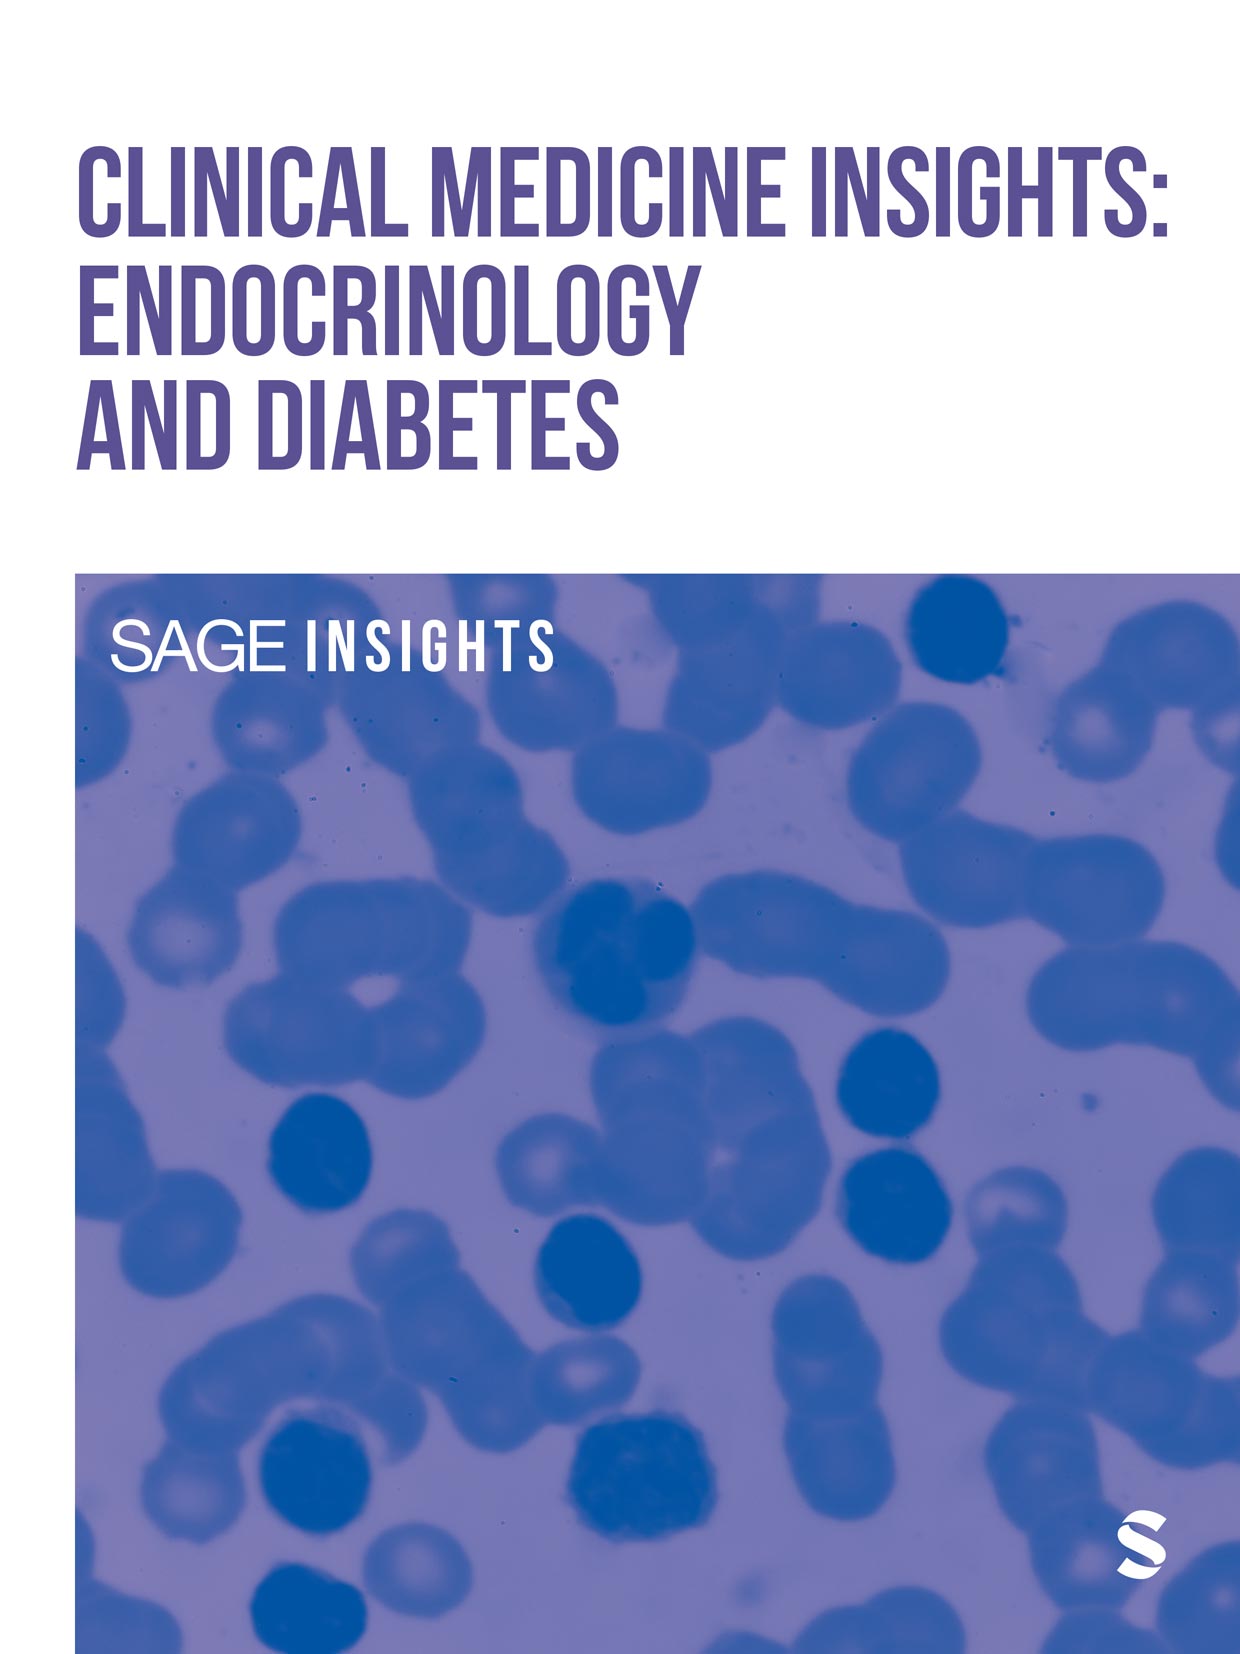

1 - 10of29 results for journals & conference proceedings Endocrinology & Metabolism
Skip to main content

Also from Sage
- CQ Library Elevating debateopens in new tab
- Sage Data Uncovering insightopens in new tab
- Sage Business Cases Shaping futuresopens in new tab
- Sage Campus Unleashing potentialopens in new tab
- Sage Knowledge Multimedia learning resourcesopens in new tab
- Sage Research Methods Supercharging researchopens in new tab
- Sage Video Streaming knowledgeopens in new tab
- Technology from Sage Library digital servicesopens in new tab